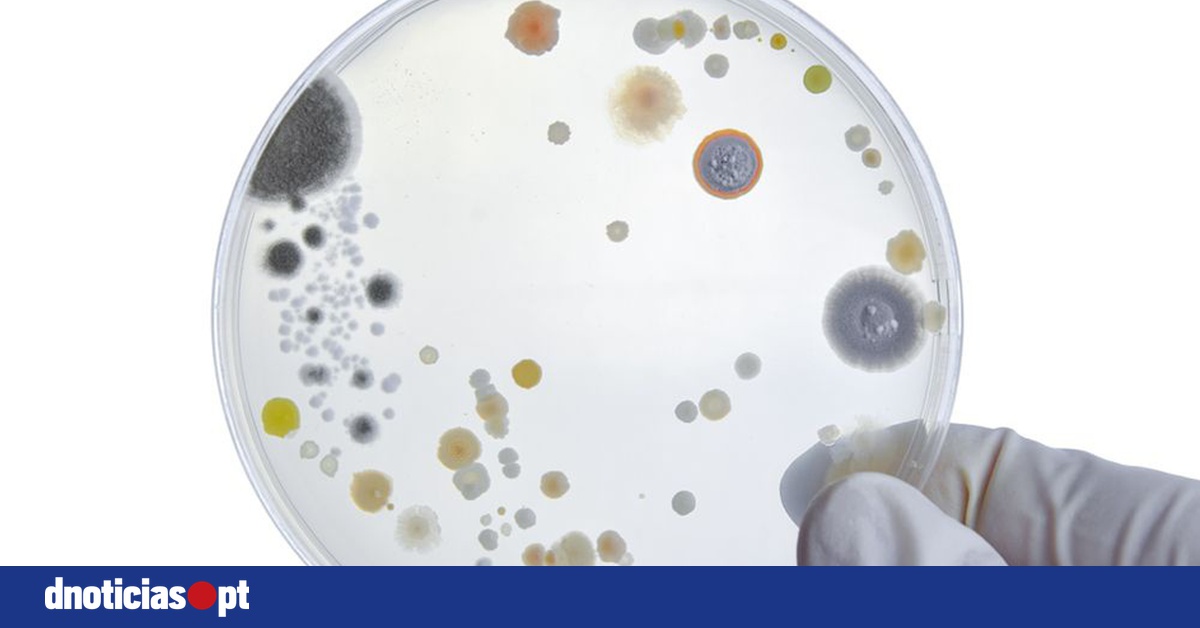
DNOTICIAS.PT

Cientistas identificam em Portugal bactéria que reduz inflamação intestinal e trava infecção

Uma equipa de cientistas em Portugal descobriu uma bactéria que ajuda a recuperar a microbiota, reduzindo a inflamação intestinal e impedindo infeção, anunciou o Instituto Gulbenkian de Medicina Molecular, onde foi conduzida a investigação com ratinhos.
A bactéria, descoberta acidentalmente, pertence ao grupo 'Klebsiella pneumoniae', na origem de infeções hospitalares, mas é inofensiva e em vez de causar doença ajuda a recuperar a microbiota intestinal, a população de microrganismos, incluindo vírus, fungos e bactérias, que habitam no intestino e desempenham uma função protetora.
"Estávamos a estudar o efeito de uma molécula química produzida pelas bactérias na capacidade da microbiota recuperar o seu estado original após a tomada de antibióticos. O efeito deste químico estava lá, mas havia algo muito mais forte que fazia com que uns ratinhos recuperassem uma microbiota saudável, capaz de proteger contra agentes infecciosos, e outros não. Esse fator determinante era a presença ou ausência desta bactéria, que até então não conhecíamos", disse à Lusa a coordenadora da equipa, Karina Xavier.
A nova estirpe recebeu a designação de 'Klebsiella sp. ARO112', sendo que ARO corresponde às iniciais do nome da doutoranda Ana Rita Oliveira, que fez parte da equipa científica.
O trabalho, descrito na publicação da especialidade Nature Communications, perspetiva novos probióticos terapêuticos, segundo o Instituto Gulbenkian de Medicina Molecular.
De acordo com Karina Xavier, serão necessários, no entanto, mais estudos para se saber com rigor qual a prevalência desta estirpe bacteriana nos humanos e a sua correlação com níveis baixos de inflamação, dado que os resultados, apesar de promissores, foram obtidos com ratinhos.
"Encontrámos esta bactéria no intestino de ratinhos, mas sabemos que está presente em ratinhos e em humanos. Só que não está presente nem em todos os ratinhos nem em todos os humanos", ressalvou a investigadora, que lidera o laboratório de sinalização bacteriana, adiantando que, num próximo passo, serão feitos testes com células de tecido intestinal humano.
Karina Xavier e restante equipa de investigação esperam que "quem já tem a bactéria, em situações que afetam a sua microbiota, vai estar mais protegido".
Nos ratinhos, os cientistas verificaram que a 'ARO112' só conseguia colonizar em níveis elevados o intestino quando os roedores tinham uma microbiota desequilibrada, com baixa diversidade, no caso por efeito da administração de um antibiótico.
"A expectativa é que a bactéria colonize em qualquer condição em que tivermos uma microbiota desequilibrada, mas coloniza a níveis muito baixos em microbiotas consideradas saudáveis", sublinhou Karina Xavier.
No laboratório, a 'ARO112' bloqueou bactérias causadoras de doença, como a 'Salmonella', e estirpes patogénicas da 'Escherichia coli', bem como reduziu patologias associadas à inflamação intestinal.
Em ratinhos com doença inflamatória intestinal e "com microbiota comprometida", a ação da 'ARO112', adicionada após exposição dos roedores a antibióticos e a infeção bacteriana, permitiu que recuperassem mais rapidamente a sua microbiota, a infeção desaparecesse e a inflamação intestinal reduzisse significativamente.
"Os antibióticos são essenciais, mas perturbam a microbiota", salientou Karina Xavier, citada no comunicado do Instituto Gulbenkian de Medicina Molecular, admitindo que no futuro o tratamento com antibióticos poderá ser acompanhado por bactérias benéficas como a 'ARO112' "para restaurar o equilíbrio intestinal".
Além disso, a administração desta bactéria, após tratamentos com antibióticos para combater infeções e inflamação, pode ser uma "alternativa precisa e segura a procedimentos como o transplante fecal".
Os cientistas fizeram vários testes de segurança e concluíram que a 'ARO112' "não apresenta nenhuma das características das bactérias causadoras de doença, ou seja, não forma biofilmes e não adquire facilmente genes de resistência a antibióticos".
"Mesmo quando lhe foi dada artificialmente uma resistência, a bactéria perdeu-a naturalmente poucos dias depois", destacou o comunicado do Instituto Gulbenkian de Medicina Molecular, referindo que a presença da 'ARO112' no intestino é temporária, desaparecendo à medida que a microbiota recupera.
O estudo reforça "a necessidade de probióticos ajustados a situações clínicas específicas", uma vez que o probiótico comercial 'E. coli Nissle 1917', já usado na Europa, revelou-se sem efeito protetor nos ratinhos estudados.
A investigação foi desenvolvida pelo Instituto Gulbenkian de Medicina Molecular em colaboração com instituições científicas espanholas e suíças.